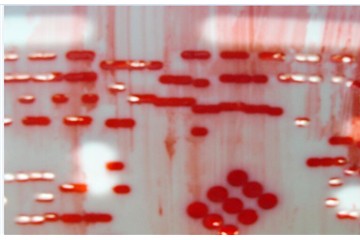

- 水基清洗剂-合明科技,为什么使用水基清洗剂是一种大方向?
- 2023-06-27浏览:295

- PCBA线路板焊接后残留物分析(一),合明科技
- 2023-06-27浏览:384

- PCBA线路板焊接后残留物分析(二)-合明科技
- 2023-06-27浏览:317

- 红胶清洗与红胶厚网有效清洗技巧介绍-红胶网板清洗剂
- 2023-06-27浏览:221
- 红胶网板清洗要怎么选择清洗剂?红胶网板清洗剂-合明科技
- 2023-06-27浏览:162

- 合明科技与你分享:PCBA线路板清洗工艺(一)
- 2023-06-27浏览:179

- PCBA线路板加工污染有哪些?-线路板清洗合明科技
- 2023-06-27浏览:186

- 二手chroma66202/致茂租售
- 2023-06-27浏览:153

- 红胶网板清洗-合明科技攻克和解决国内外行业红胶网板清洗难题
- 2023-06-27浏览:170

- 贵州工程涂料厂家 工程漆厂家 贵阳工程漆/涂料定制
- 2023-06-26浏览:287

- 重庆水性油漆 水性油漆涂料 颜色多样
- 2023-06-26浏览:228

- 重庆铝粉金属氟碳漆漆膜耐老化-附着力强
- 2023-06-25浏览:262

- 重庆水性氟碳漆耐侯防腐-漆膜鲜艳
- 2023-06-25浏览:146

- 重庆地面防腐漆生产厂家-益辉涂料厂
- 2023-06-25浏览:153

- 武汉大金空调售后维修电话,武汉大金空调区域服务号码查询
- 2023-06-24浏览:109

- 武汉LG空调售后维修电话,武汉LG空调区域服务号码查询
- 2023-06-24浏览:132

- 武汉科龙空调售后维修电话,武汉科龙空调区域服务号码查询
- 2023-06-24浏览:85

- 武汉志高空调售后维修电话,武汉志高空调区域服务号码查询
- 2023-06-24浏览:94

- 武汉奥克斯空调售后维修电话,武汉奥克斯空调区域服务号码查询
- 2023-06-24浏览:100

- 武汉海尔空调售后维修电话,武汉海尔空调区域服务号码查询
- 2023-06-24浏览:828